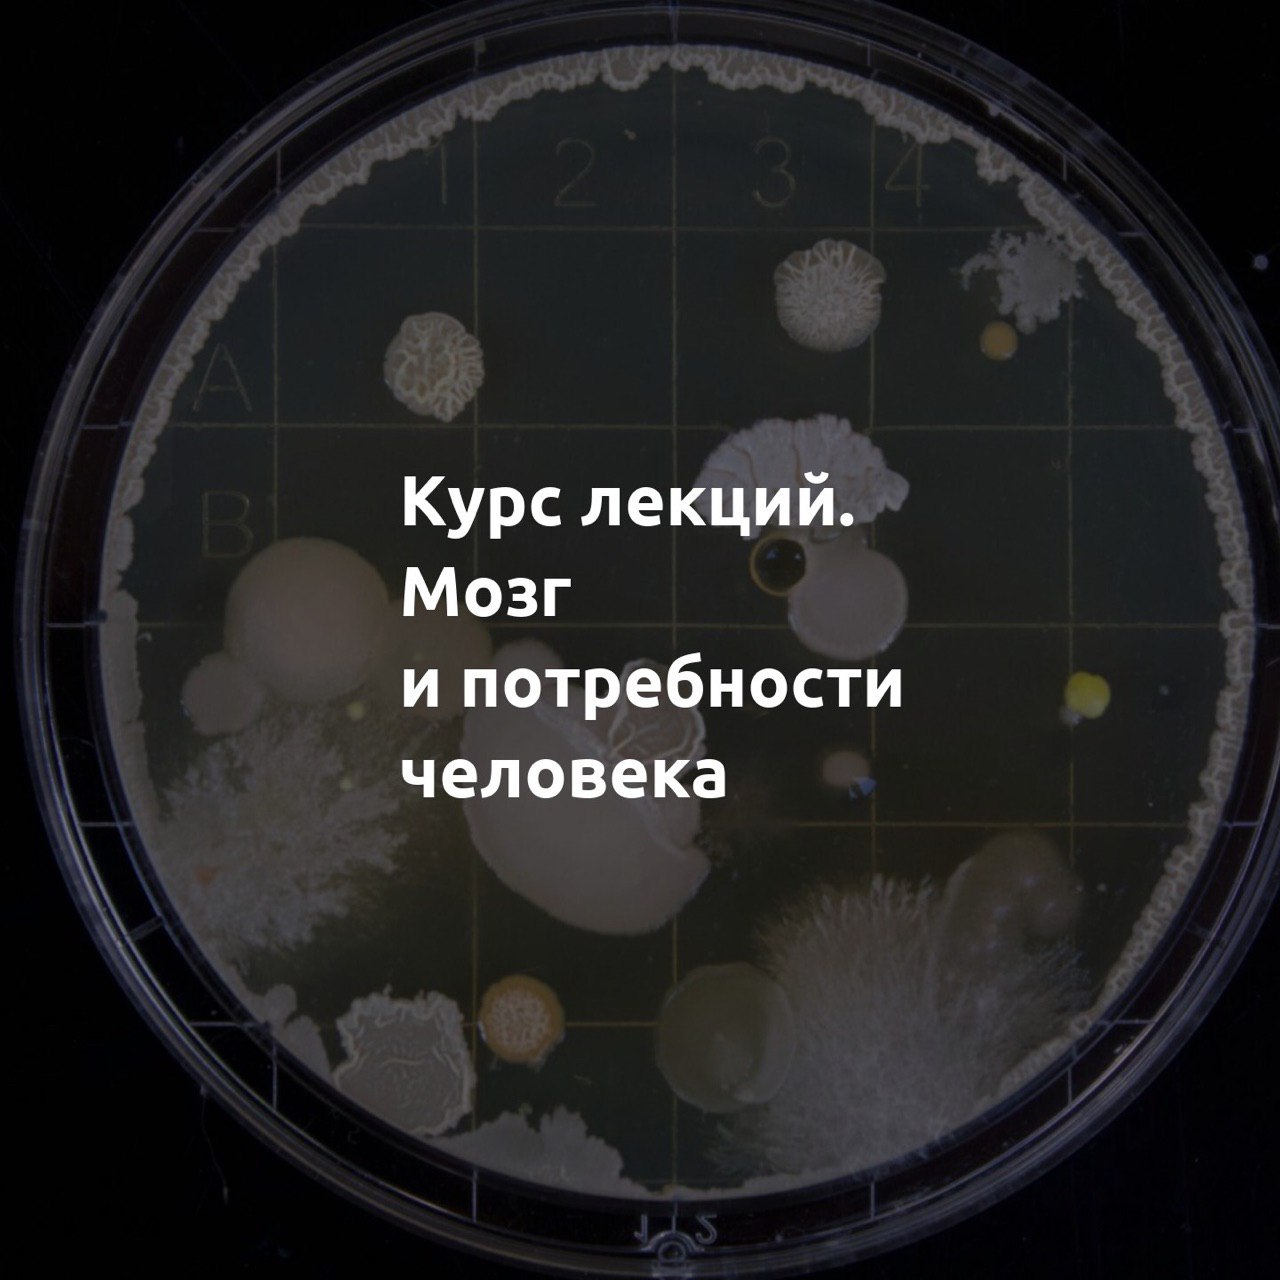

Почему нас радует еда и всё новое? Как работает юмор и формируются привязанности? В чём истинные причины агрессии и стремления к лидерству? Чем полезен страх?
В курсе с позиций современной нейрофизиологии рассказывают о принципах функционирования мозга, формировании потребностей у человека и животных, эволюции поведения и воздействии гормонов.
В каждой лекции объясняют конкретную биологическую потребность: пищевую, исследовательскую, родительскую, потребность в безопасности и другие.
Плейлист на Youtube
https://youtu.be/ejmiYbbRnSc
Видео с сайта лектория МГУ
http://media.msu.ru/?s=Мозг+и+потребности+человека
Презентации с лекций
http://www.bio.msu.ru/dict/view.php?ID=351

















